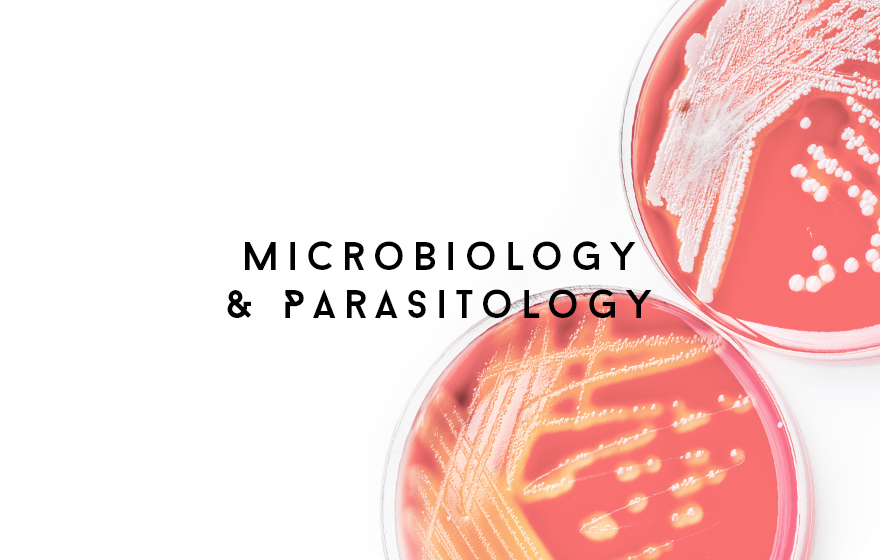

Course Information for Students & Clinical Supervisors
MYF information can be found here

Student Support Area
In this section of the website, there are a number of topics that may be of use for students whilst working towards their qualification

Coaching for Students
Second year students are able to book coaching sessions with Emily here

Clinical Supervisors Information
MYF information can be found here

Dip Apr 26 - Jul 28 Term 1 - Tuesdays
This is the area where your lectures for the term will be located

Dip Jan 26-28 Term 1 - Mondays
This is the area where your lectures for the term will be located

Jan 26 - 28 Term 2
This is the area where your lectures for the term will be located

Dip Apr 25-27 Term 1 Tuesdays
This is where your lectures for the first term will be uploaded

Dip Apr 25-27 Term 2
This is where your lectures will be uploaded

Dip Jan 25-27 Term 2
This is the area where you can find your lectures for the term

Dip Jan 25 - 27 Term 1 - Mondays
This is the area where you can find your lectures for the term

Dip Jan 25 - 27 Term 3
This is the area where you can find your lectures for the term

Dip Jan 25 - 27 Term 4 - Tuesdays
This is the area where you can find your lectures for the term

Dip Jan 25 - 27 Term 5
The summer term's lectures are available here

Dip Sept 24 - 26 Term 1 - now Thursdays
This is where your lectures for the first term will be posted after each day

Dip Sept 24-26 Term 2
This is where your lectures for the first term will be posted after each day

Dip Sept 24-26 Term 3
This is where your lectures for the term will be posted after each day

Dip Sept 24-26 Term 4
This is where your lectures for the term will be posted after each day

Dip April 24 - 26 Term 1 - now Wednesdays
This is where your lectures will be posted each week.

Dip Apr 24 - 26 Term 2
This is where your lectures will be posted each week.

Dip Apr 24-26 Term 3
This is where your lectures will be posted each week.

Dip Apr 24-26 Term 4
This is where your lectures will be posted each week.

Dip Apr 24- 26 Term 5
This is where your lectures will be posted each week.

Dip Apr 24-26 Term 6
This is where your lectures will be posted each week.

Dip A25-27 Exam Bookings (Timetabled Exams)
This is where you are able to book your timetabled exams

DipJ25-27 Exam Bookings (Timetabled Exams)
This is the area where you can find your lectures for the term

DipS24-26 Exam Bookings (Timetabled Exams)
This is where your lectures for the first term will be posted after each day

DipA24-26 Exam Bookings (Timetabled Exams)
This is the area where you can enter upcoming exams

VTEC VN01 Assignment Submissions
This is the area where you are able to submit VTEC VN01 assignments

VTEC VN04 Assignment Submissions
This is the area where you are able to submit VTEC VN04 assignments

VTEC VN07/08/09 First 2 cases Submissions
This is the area where you are able to submit the first two cases for your VTEC VN07-08-09 assignment

VTEC VN07/08/09 Full Assignment Submissions
This is the area where you are able to submit VTEC VN07/08/09 assignments

VN04 Additional Evidence Submissions
This is the area where you are able to submit VTEC VN04 assignments
VetSkill PD and OSCE Preparation
Videos and material to help you prepare for the OSCEs and Professional Discussion

Booking Area for Professional Discussion Mock Exams
Once you have submitted the paperwork needed for you to be entered for your End Point Assessment and it has been uploaded to the Gateway portal, you will be able to access this area, and book yoursel…
VetSkill OSCE Presentation
This recorded presentation has been prepared by VetSkill, and you will be given access to this when your OSCE sitting is confirmed and you have received your time slot.
CS Update
Area where existing CSs can be directed to get updated

Dip Jan 24 - 26 Term 1 - now Fridays
This is the area where your lectures will be uploaded for your first term

Dip Jan 24 - 26 Term 2
This is the area where your lectures will be uploaded

Dip Jan 24 - 26 Term 3
This is the area where your lectures will be uploaded

Dip Jan 24-26 Term 4
This is the area where your lectures will be uploaded

Dip Jan 24-26 Term 5
This is the area where your lectures will be uploaded

Dip Jan 24-26 Term 6
This is the area where your lectures will be uploaded

Dip Jan 24-26 Term 7
This is the area where your lectures will be uploaded

Dip Sept23-25 Term 7
This is where you will find this term's lectures

Dip Sept 23-25 Term 6
This is where you will find this term's lectures

Dip Sept 23-25 Term 5
This is where you will find this term's lectures

Dip Sept 23 - 25 Term 4
This is where you will find this term's lectures

Dip Sept 23 - 25 Term 3
This is where you will find this term's lectures

Dip Sept 23 - 25 Term 2
This is where you will find this term's lectures

Dip Sept 23 - 25 Term 1 - now Fridays
This is where you will find this term's lectures

Dip Sept 23-25 Term 7
This is where you will find this term's lectures

Dip Sept 23-25 Term 6
This is where you will find this term's lectures

Dip Sept 23-25 (F) Term 5
This is where you will find this term's lectures

Dip Sept 23 - 25 Term 4
This is where you will find this term's lectures

Dip Sept 23 - 25 Term 3
This is where you will find this term's lectures

Dip Sept 23 - 25 Term 2
This is where you will find this term's lectures

Dip Sept 23 - 25 Term 1 - now Wednesdays
This is where you will find this term's lectures

Dip Apr 23-25 Term 6
This is where you'll find your lectures for this term

Dip Apr 23 - 25 Term 5
This is where you'll find your lectures for this term

Dip Apr 23 - 25 Term 4
This is where your lectures are for the period April - July 2024

Dip Apr 23 - 25 Term 3
This is where your lectures are for the period Jan - Mar 24

Dip Apr 23 - 25 Term 2
This is where your lectures will be made available after each week so
you can go back and review them at your leisure when you need to remind
yourself of the content

Dip Apr 23 - 25 Term 1 - now Wednesdays
This is where your lectures will be made available after each week so
you can go back and review them at your leisure when you need to remind
yourself of the content

Dip Jan 23-25 Term 7
This term's lectures will be available here

Dip Jan 23 - 25 Term 6
This term's lectures will be available here

Dip Jan 23 - 25 Term 5
This term's lectures will be available here

Dip Jan 23 - 25 Term 4
This term's lectures will be available here

Dip Jan 23- 25 Term 3
This term's lectures will be available here

Dip Jan 23 - 25 Term 2
This term's lectures will be available here

Dip Jan 23 - 25 Term 1 - now Fridays
This is where your lectures will be made available after each week so you can go back and review them at your leisure when you need to remind yourself of the content

Dip Sept 22 - 24 Term 7
Course notes and presentations for this term's lectures will be posted here

Dip Sept 22 - 24 Term 6
Course notes and presentations for this term's lectures will be posted here

Dip Sept 22 - 24 Term 5
Course notes and presentations for this term's lectures will be posted here

Dip Sept 22 - 24 Term 4
Course notes and presentations for this term's lectures will be posted here

Dip Sept 22 - 24 Term 3
Course notes and presentations for this term's lectures will be posted here

Dip Sept 22 - 24 Term 2
Course notes and presentations for this term's lectures will be posted here

Dip Sept 22 - 24 Term 1
Course notes and presentations for the first term will be posted here

Dip Sept 22 - 24 Term 7
Lectures will be posted here each week for your reference

Dip Sept 22 - 24 Term 6
Lectures for the period April - July 2024 will be posted here

Dip Sept 22 - 24 Term 5
Lectures for the period Jan - Mar 2024 will be posted here

Dip Sept 22 - 24 Term 4
Lectures for the period Sept - Dec 2023 will be posted here

Dip Sept 22 - 24 Term 3
Lectures for the period April - July 2023 will be posted here

Dip Sept 22 - 24 Term 2
Lectures for the period Jan - March 2023 will be posted here

Dip Sept 22 - 24 Term 1
This is where the first term's lectures for the Diploma September 2022 - 2024 group attending on Mondays will be posted

Dip Apr 22 - 24 Term 7 (Wednesdays)
Lecture material for this term will be posted here

Dip Apr 22 - 24 Term 6
Lecture material for this term will be posted here

Dip Apr 22 - 24 Term 5
Lecture material for this term will be posted here

Dip Apr 22-24 Term 4
Lecture material for this term will be posted here

Dip Apr 22-24 Term 3
Lecture material for Jan - Mar 23 will be posted here

Dip Apr 22 - 24 Term 2
Lecture material for Sept - Dec 22 will be posted here

Dip Apr 22 - 24 Term 1
Course notes and lecture presentations will be available here

Fridays Jan 22-24 Jan - Mar 24
Lectures for this term will be posted here

Tuesdays Dip Jan 22-24 Sept - Dec 23
Lectures for this term will be posted here

Tuesday Jan 22 - 24 Apr - Jul 23
Lectures for this term will be posted here

Tuesday Jan 22 - 24 Jan - Mar 23
Lectures for this term will be posted here

Monday Jan 22-24 Sept - Dec 22
Lectures for the period September to December 2022 will be found here

Monday Jan 22 - 24 April - July 22
Lectures and information for the period April - July 2022 can be found here

Monday January 2022 starts: Jan - Mar 22 (now Fridays)
Lectures starting from January 2022

Fridays Dip Sept 21 - 23 Sep-Dec 23
Lectures for the period Jan - March 2023 will be posted here

Thursdays Sept 21 - 23 Apr - Jul 23
Lectures for the period Apr - Jul 2023 will be posted here

Thursdays Sept 21 - 23 Jan - Mar 23
Lectures for the period Jan - March 2023 will be posted here

Thursdays Sept 21 - 23 Sept - Dec 22
Lectures for the period September - December 22 will be posted here

Sept 21 starts April - July 2022
Lectures for the April - July 2022 term will be posted here

Sept 21 starts: Jan - Mar 22
Lectures for the period January - March 2022 will be posted here

September 2021 starts: Sept - Dec 21 (now Friday)
Lectures for the period September - December 2021 will be posted here

Fridays Sept 20-22 Sept - Dec 2022
Lectures for the period Sept - Dec 2022 will be posted here for you

Sept 20 starts April - July 2022
Lectures for the period April to July 2022 will be posted here for you

Sept 20 starts Jan - Mar 22
Presentations and lectures for the period from January to March 2022

Thursday Group - September 2020 starts Sept - Dec 2021
Presentations and lectures for the period from September to December 2021

Wednesday Group September 20 starts: April - July 21 (now Thursdays)
Lectures and Information for April - July 2021

September 2020 starts: January - March 21 (now Thursdays)
Lectures and notes for January - March 2021

September 2020 starts Sept - Dec 20
Lectures & information for Sept - Dec 2020